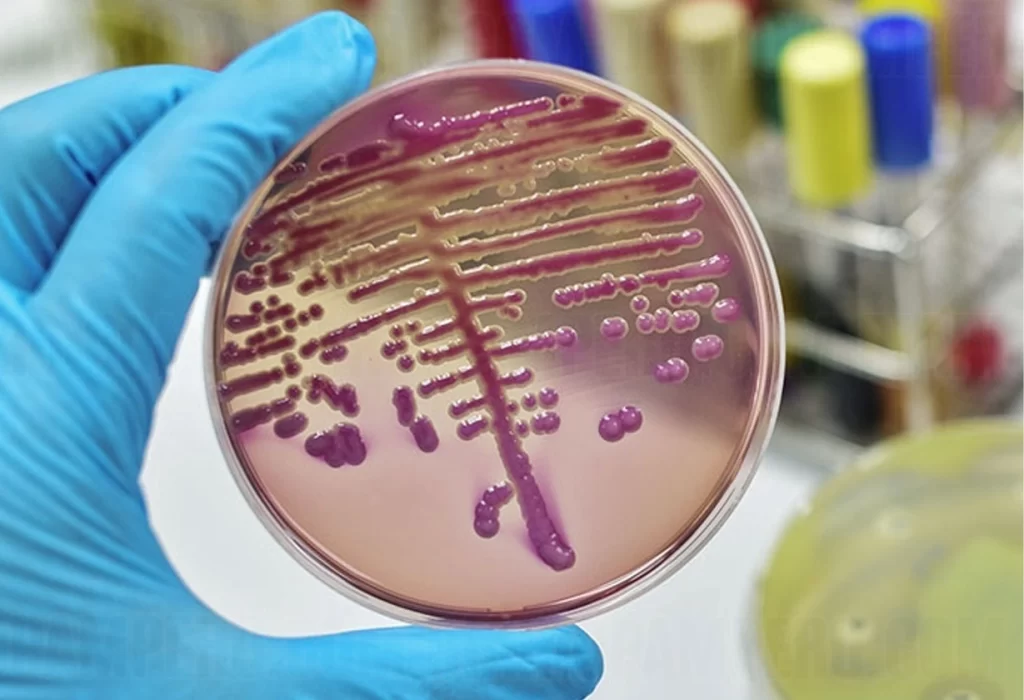

Aumento Alarmante de Casos Invasivos por Estreptococo: Advierten sobre Síntomas y Recomiendan Consulta Médica
Alerta Mundial por Aumento de Casos Invasivos de Estreptococo: Síntomas, Prevención y Llamado a la Cooperación Internacional
Incremento preocupante y llamado a la acción
El último Boletín Epidemiológico Nacional ha desvelado un aumento alarmante en los casos de infecciones invasivas provocadas por la bacteria estreptococo pyogenes. Con 643 casos confirmados y un 14.4% de fallecimientos hasta el 18 de noviembre, los expertos, encabezados por el médico infectólogo Martín Hojman de la Sociedad Argentina de Infectología (SADI), lanzan una alerta a la población. Se insta a estar vigilantes ante síntomas como dolor de garganta, fiebre y erupción cutánea, y se subraya la urgencia de buscar atención médica rápidamente.
Desafíos y resistencia bacteriana
El estreptococo pyogenes, conocido también como Streptococcus del grupo A (SGA), ha mostrado resistencia en algunas muestras analizadas en Argentina, planteando desafíos significativos para su contención. La distribución por edad revela un impacto notorio en menores de 16 años, con el 36.6% de los casos fallecidos en este grupo. Además, la Organización Mundial de la Salud ha informado sobre un aumento similar en Estados miembros de la región europea, generando preocupaciones a nivel global. Esta resistencia bacteriana resalta la necesidad apremiante de medidas preventivas para frenar la propagación y evitar pérdidas de vidas adicionales.
Recomendaciones y estrategias de prevención
Ante la situación crítica, el Ministerio de Salud argentino y la Organización Mundial de la Salud subrayan la importancia de la consulta médica temprana. Además, se hace hincapié en completar los tratamientos con antibióticos según las indicaciones médicas, advirtiendo sobre los riesgos de la automedicación. El Laboratorio Nacional de Referencia ha identificado linajes de la bacteria, previamente descritos en el Reino Unido y Dinamarca, que presentan una alta virulencia. Estas cepas emergentes ponen de manifiesto la necesidad de estrategias efectivas de prevención y control para contrarrestar la evolución de la enfermedad.
Impacto global y llamado a la cooperación internacional
El aumento de casos invasivos por estreptococo pyogenes no se limita a Argentina; informes de la Organización Panamericana de la Salud y los Centros para la Prevención y el Control de Enfermedades de Estados Unidos señalan incrementos en otros países. En vista de esta realidad, se lanza un llamado urgente a la cooperación internacional. Se destaca la importancia de compartir información, recursos y estrategias exitosas para combatir esta creciente amenaza global para la salud pública. La colaboración entre naciones se erige como un pilar fundamental para abordar de manera efectiva esta emergencia sanitaria.
DESCARGAR APLICACIÓN DE LA RADIO EN VIVO
Gracias por estar en Diario Pampero, visítanos para estar informado!
Si necesitas parte de este contenido, no olvides citar la fuente de información. Respetamos a quienes producen contenidos, artículos, fotos, videos. Compartimos información de La Pampa para los pampeanos y te informamos sobre toda la actualidad nacional e internacional destacada.
Si compartes nuestro contenido, nos ayudas a crecer como medio de comunicación!







